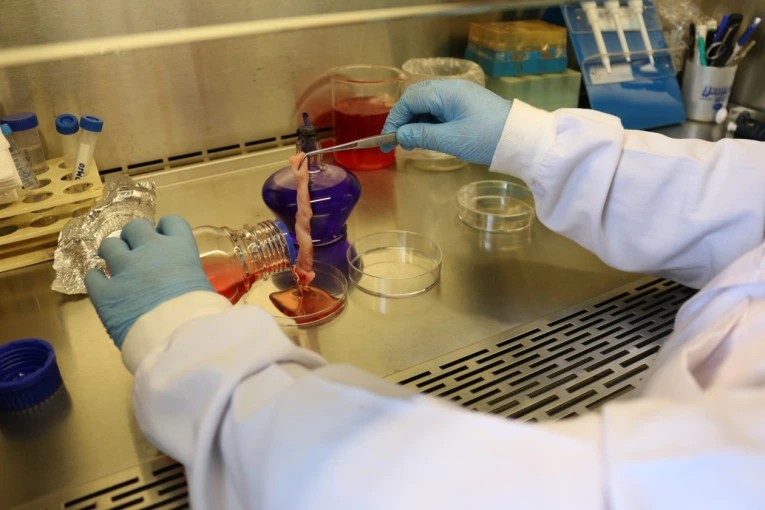
Hanya 5% Kampus di Indonesia Berorientasi Riset, Kegiatan Pengabdian Perlu Digalakkan

Schoolmedia News Jakarta ----- Pemerintah mulai memberlakukan kebijakan minyak goreng Rp14.000 per liter hari ini, Rabu (19/01/2022). Menteri Koordinator Bidang Perekonomian (Menko Ekon) Airlangga Hartarto menegaskan bahwa kebijakan ini berlaku di seluruh Indonesia.
“Pemberlakuan kebijakan satu harga untuk minyak goreng yakni sebesar Rp14.000,00 per liter akan di mulai pada hari Rabu tanggal 19 Januari 2022 pukul 00.00 WIB di seluruh Indonesia. Namun, khusus untuk pasar tradisional diberikan waktu penyesuaian selambat-lambatnya 1 minggu dari tanggal pemberlakuan,” ujar Airlangga, dikutip dari laman resmi Kemenko Perekonomian, Rabu (19/01/2022).
Sebelumnya, pemerintah telah memutuskan untuk meningkatkan upaya menutup selisih harga minyak goreng demi memenuhi kebutuhan rumah tangga, industri mikro, dan industri kecil. Kebijakan ini didasarkan atas hasil evaluasi yang mempertimbangkan ketersediaan dan keterjangkauan harga minyak goreng bagi masyarakat.
Menindaklanjuti kebijakan sebelumnya, pemerintah memastikan kembali agar masyarakat dapat memperoleh harga minyak goreng kemasan dengan harga terjangkau, yaitu Rp14.000 per liter. Upaya menutup selisih harga ini tidak hanya diberikan untuk minyak goreng kemasan 1 liter, tetapi juga diberikan untuk minyak goreng dalam kemasan 2 liter, 5 liter, dan 25 liter.
“Diputuskan bahwa untuk selisih harga minyak goreng akan diberikan dukungan pendanaan dari Badan Pengelola Dana Perkebunan Kelapa Sawit (BPDPKS) sebesar Rp7,6 triliun,” ujar Menko Ekon.
Minyak goreng kemasan dengan harga khusus tersebut akan disediakan sebanyak 250 juta liter per bulan selama jangka waktu 6 bulan. Pemerintah juga akan terus melakukan monitoring dan evaluasi secara rutin, minimal satu bulan sekali, terkait dengan implementasi kebijakan ini.
Sebelumnya, Presiden dalam pernyataannya di awal Januari lalu telah memerintahkan jajarannya untuk menjamin stabilitas harga minyak goreng di dalam negeri. Seperti diketahui, harga minyak sawit mentah atau crude palm oil di pasar ekspor sedang tinggi.
“Sekali lagi, prioritas utama pemerintah adalah kebutuhan rakyat. Harga minyak goreng harus tetap terjangkau. Jika perlu, Menteri Perdagangan bisa melakukan lagi operasi pasar agar harga tetap terkendali,” ujar Presiden.
Tim Schoolmedia

Tinggalkan Komentar